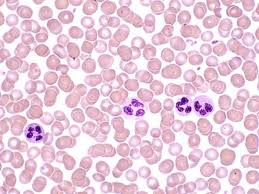

Is the picture below, human blood or animal blood?
Is the picture below, human blood or animal blood?
In an attempt to hide evidence, a perpetrator may try to remove blood evidence by _______________ the area.
Red blood cells contain _______________, the iron-bearing protein that carries oxygen.
To detect hemoglobin, an investigator mixes Luminol powder with _________________ in a spray bottle.
Kastle-Meyer test. If blood is present, a _______________ color is produced.
______________________. This chemical undergoes a color change, producing a green color in the presence of blood.
One test known as an ___________ test (Enzyme Linked Immunosorbent Assay) involves an antibody–protein reaction.
When a sample of human blood is mixed with some of these anti-human antibodies produced by the _______ or other animal, a positive reaction will occur, and the presence of human blood is confirmed.
Blood Reagent Tests. These tests, referred to as ________________, are used to detect blood at crime scenes based upon the properties of hemoglobin in the blood.
Investigators will first examine the crime scene to look for areas that may contain blood. They may use a high-intensity light or _____ lights to help them find traces of blood as well as other bodily fluids that are not visible under normal lighting conditions.
Is the picture below, human blood or animal blood?
Is the picture below, human blood or animal blood?

The person’s blood type is determined by examining __________________ reactions.
A German biologist, ______________, developed a test that could be used to differentiate between blood and other types of stains.
Seventeen spots of human blood were identified, as well as several stains of __________________.
On Christmas Eve in 1975, Tommy Zeigler was found shot in his store. His wife, her parents, and a __________ worker were also found dead.
______________________ was accused of killing his neighbor and attempting to kill his wife to collect his wife’s life insurance.
When police arrived at the Backhouse home, the neighbor, Colyn Bedale-Taylor, was found dead from shotgun wounds. Backhouse had sustained wounds to his chest and face. He claimed _______________.
He trained in internal medicine and pathology at Bellevue Hospital, and then worked in the Office of the
Chief Medical Examiner in New York City from 1961 to 1986, serving as the ___________________ from 1978 to 1979.
He served as an expert witness in the O.J. Simpson trial. Dr. Baden was the forensic pathologist member of
a team of U.S. forensic scientists asked by the Russian government to examine the remains of Tsar Nicholas II of Russia and other members of the ______________ family found in Siberia in the 1990s.
Dr. Baden calls himself “a ___________ for the dead.’’